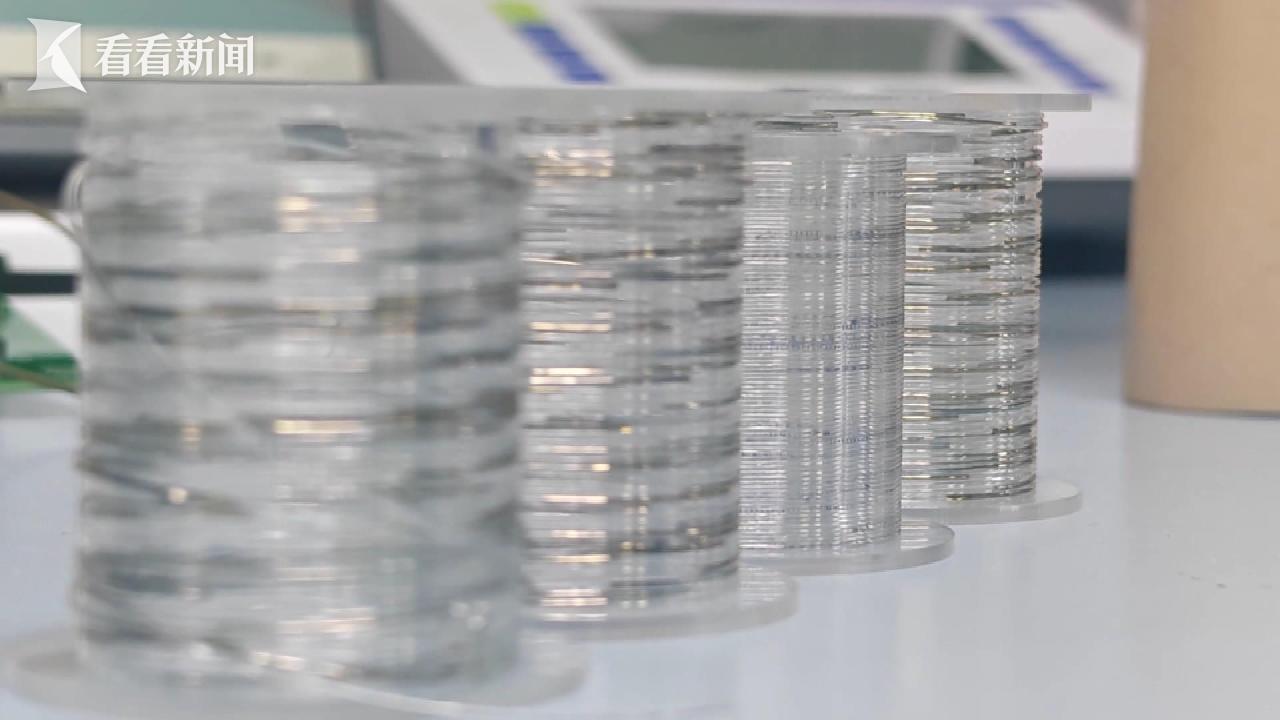

在一根比头发丝还细的纤维中构建高密度集成电路,这一曾被视为大胆设想的技术,如今已成为现实。复旦大学研究团队突破传统硅基芯片的集成电路研究路径,成功研制出全球首创的“纤维芯片”,相关研究成果今天正式发表在国际权威学术期刊《自然》主刊上。

记者看到,这段细如发丝的纤维,正是复旦大学彭慧胜、陈培宁团队的最新研究成果。研究团队在一厘米长度的纤维内,集成了20至30个可独立控制的发光像素点,每一个像素的亮度和点位都可以进行程序化调控。更重要的是,这种纤维芯片无需依赖外部驱动系统,所有发光控制都能在仅约4厘米的纤维内部完成。

复旦大学纤维电子材料与器件研究院先进材料实验室博士生王臻介绍说,纤维芯片未来还可以进一步集成传感和储能功能,实现“自供能”的完整电子系统。“后续可以在纤维内部加入触觉传感等模块,让它在提供能量的同时,具备感知和信息处理能力。”

传统芯片的信息处理能力,依赖于大量微型电子元件通过高度互连形成的集成电路。但长期以来,纤维电子系统主要依靠外部连接的硬质块状芯片,这与纤维本身柔软、可弯折、适应复杂形变的应用需求存在根本矛盾。

破解这一难题的关键,在于跳出“只利用纤维表面”的传统思路。研究团队创新性提出了多层旋叠架构设计,在柔性高分子材料内部构建多层集成电路结构,使纤维不再只是“载体”,而成为真正的集成系统。
王臻表示,相比单纯利用纤维表面,这种设计可利用的空间提升了100倍以上。研究团队在5微米的加工精度下,实现了每厘米纤维集成约10万根晶体管的密度,达到了硅基芯片中超大规模集成电路的水平。
这一突破性成果,不仅为可穿戴设备、智能织物等应用提供了全新技术路径,也为未来柔性电子系统的发展打开了新的想象空间。

相比于传统芯片,“纤维芯片”具有优异的柔性,可耐受弯曲、拉伸、扭曲等复杂形变,如承受1毫米半径弯曲、30%拉伸形变、180°/厘米扭转等变形,甚至在经过水洗、高低温、卡车碾压后,仍能正常工作。

专家表示,“纤维芯片”并不是要取代传统的硅基芯片,而是在探索一条全新的技术路径。复旦大学纤维电子材料与器件研究院教授陈培宁指出,相比传统的硅基或硬质芯片,纤维芯片的优势在于其独特的一维结构和良好的柔性特征,能够适应弯折、拉伸等复杂形变环境。
芯片做进纤维里,技术难度究竟有多高呢?可以这样说,相当于在头发丝里“雕花”。
纤维是曲面结构,且每厘米的表面积仅0.01到0.1平方厘米。复旦研究团队另辟蹊径,不局限于纤维表面,而是构建螺旋式多层电路,最大化利用了纤维内部空间。按实验室1微米光刻精度推算,1毫米长的纤维目前可集成1万个晶体管,与一些商业医用植入芯片相当。

另外,传统芯片依赖硅晶圆的平整表面,而构成纤维基底的弹性高分子材料表面像“崎岖山地”,无法直接光刻。

团队用等离子刻蚀技术,将其表面粗糙度降至1纳米以下,达到商业光刻要求,打破了“芯片只能刻在硅片上”的传统认知。

而第三个难关,是稳定性的挑战,要让纤维芯片在复杂变形下仍能稳定工作。
复旦大学纤维电子材料与器件研究院先进材料实验室博士生陈珂介绍,纤维芯片在结构上具备出色的柔韧性和可靠性。她表示,团队围绕弯曲和弯折这一核心工况,对样品进行了上万次甚至十万次的反复测试,纤维芯片依然能够稳定工作,性能未出现明显衰减。

在更极端的条件下,研究人员还对纤维芯片进行了重载测试。即便在一辆重达15.6吨的大型卡车碾压之后,其关键性能仍然保持不变,显示出良好的机械耐受性和应用潜力。
历时5年集中攻关,再加上此前数年的探索积累,最终,复旦大学研究团队实现了每厘米10万个晶体管的集成密度。更关键的是,其制备工艺与现有成熟光刻工艺有效兼容,为规模化制造打下基础。
由于其特殊的柔韧性,纤维芯片和传统芯片相比,应用领域更加广泛。比如,额可以编织成柔软、透气的电子织物。在远程医疗机器人手术等场景中,纤维芯片做成的智能触觉手套,可以精准模拟不同物体的力学触感。

而在脑机接口等关键领域,纤维芯片就更能展现独特价值了。复旦大学纤维电子材料与器件研究院先进材料实验室教授陈培宁表示,与以往主要承担单一传感功能的植入式器件不同,纤维芯片有望将完整的闭环功能集成在一根纤维中,实现真正意义上的全柔性系统植入,从而直接在大脑内部构建信息交互通路,有望实现更高效的信号检测和实时干预。

目前,研究团队在持续提升“纤维芯片”性能的同时,也正以应用需求为导向,加快与跨学科团队及产业界的协同合作,推动科研成果从实验室走向实际应用。团队希望在脑机接口、电子织物、虚拟现实等多个前沿领域实现突破,让这项创新技术以更广泛、更高质量的方式融入未来生活。
| 编辑: | 周缇 |
| 责编: | 张蕴昆 |

剑网行动举报电话:12318(市文化执法总队)、021-64334547(市版权局)
Copyright © 2016 Kankanews.com Inc. All Rights Reserved. 看东方(上海)传媒有限公司 版权所有

全部评论
暂无评论,快来发表你的评论吧